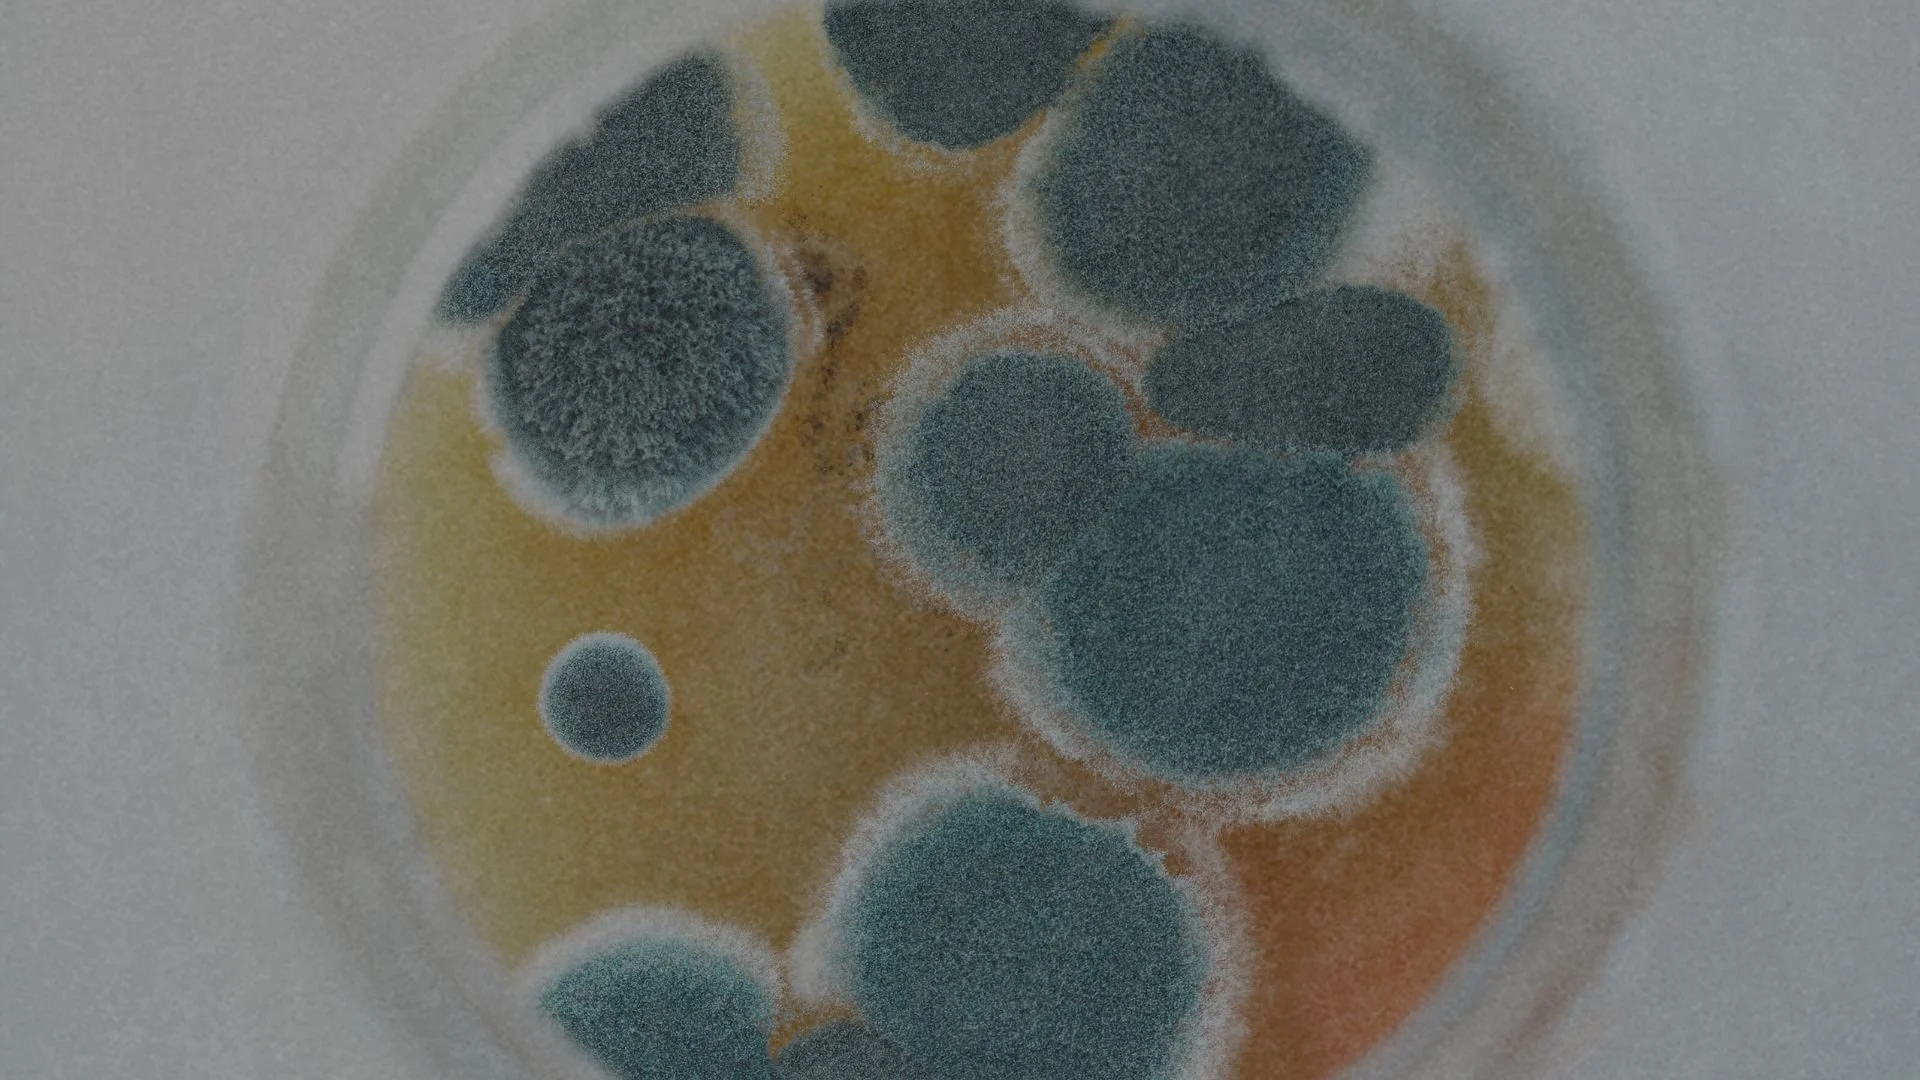

Our lifestyle shielded us from mold — mostly.
When We Realized Something Was Off
At first, it was easy to dismiss.
The stress of moving.
Dallas allergies.
Teen hormones.
Perimenopause.
Just life.
We weren’t getting super sick — no hospital visits, no debilitating symptoms. But every 4 to 6 weeks, someone in our house was down for the count. A cold that lingered. A cough that wouldn’t quit. Random stomach issues. The kind of things you chalk up to "just being run down."
And honestly? We bounced back quickly, thanks to the literal apothecary in my house.
We eat exceptionally clean. We make “low-tox” living a priority. We had all the tools — herbs, immune modulators, detox protocols. I 100% believe they kept us from getting as sick as we could have.
But then there were the weird things.
My teenage daughter and I both started shedding more hair — but we have a ton of it, so it wasn’t super obvious at first.
We were exhausted all the time, no matter how much we slept.
The brain fog was real. Conversations felt harder. Tasks felt heavier. Words became difficult to find.
The mood swings? Let’s just say they weren’t fun for anyone.
It wasn’t until the owner told us about a leak that had been happening for years that everything clicked.
Mycotoxins had been a hidden enemy living in our home.
What Are Mycotoxins?
Mycotoxins are toxic compounds produced by mold. They’re sneaky. You don’t have to see mold for them to be present. They float through the air, land in your food, and settle into your body — quietly disrupting your health.
Common Mycotoxins That Affect Health:
Aflatoxins – Found in peanuts, corn, and grains
Ochratoxin A – Found in coffee, dried fruit, and wine
Patulin – Found in apples and apple-based products
Deoxynivalenol (DON) – Found in wheat and cereal grains
Mold loves damp, humid environments — hello, Texas summers! But even if you live in a drier climate, your home isn’t immune.
Symptoms of Mycotoxin Exposure
The tricky part? Mold exposure symptoms can look like a hundred different things.
The "Normal" Symptoms We Brushed Off
✔ Feeling run-down all the time
✔ Getting sick every month or so
✔ Hair shedding (but not enough to panic over)
✔ Sleep that never felt restorative
✔ Brain fog and forgetfulness
✔ Mood swings
The Symptoms That Made Us Start Asking Questions
🚩 Constant post nasal drip
🚩 Unexplained body aches and inflammation
🚩 Anxiety or depression that didn’t feel situational
🚩 Weird digestive issues — bloating, nausea, irregularity
🚩 Skin issues — itching, under eye circles, rashes, breakouts
We weren’t falling apart, but we weren’t thriving either.
Why Didn’t We Get as Sick as We Could Have — Things that Helped Us Detox
When we started learning more about mold toxicity, and talking to a variety of doctors and practitioners, it was clear — our lifestyle choices had been quietly protecting us all along.
Our family follows an organic low-histamine diet — a shift that started with my husband’s battle with histamine intolerance. What felt like a challenge at the time turned out to be a blessing in disguise, reshaping the way we eat and live in ways that have benefited our whole family while living in mold.
This is not to say we haven’t been affected (we’re still on the path to healing), but so many of the investments we’ve made in our health helped keep us from getting completely wrecked by mycotoxin exposure.
Lifestyle Choices that Played a Huge Role in Protecting Our Health
There’s a lot of information below. Don’t let it overwhelm you. Start where you can and with what your budget allows. The “*” marks things we immediately implemented after discovering mold in our home.
-
✔ No synthetic air fresheners or candles – Opt for beeswax candles or essential oil diffusers.
✔ No bleach or ammonia-based cleaners – Use vinegar, hydrogen peroxide, or non-toxic brands.
✔ HEPA air filters + dehumidifiers (IQ Air or Air Doctor0 – Keep indoor humidity below 50% to prevent mold growth.
✔ Ditch plastic food storage – Use glass, stainless steel, or silicone to avoid mold-friendly condensation.
✔ Non-toxic laundry detergent – Conventional brands contain fragrances and endocrine disruptors that can worsen mold symptoms.
✔ Mold-resistant mattress & pillows – Opt for organic cotton, wool, or latex to prevent moisture buildup.
✔ Air purifying plants – Spider plants, peace lilies, and snake plants naturally help remove toxins from the air.
✔ Ventilation & air exchange – Keep windows open when possible and use exhaust fans in bathrooms/kitchens to prevent humidity buildup.
✔ Shoes off at the door – Prevent tracking mold spores inside your home.
✔ Dust & vacuum regularly – Use a HEPA-filter vacuum to trap mold spores and toxins.
✔ Drink good, clean water – Hydration is key for detox; make sure you’re drinking purified water free from contaminants.
✔ Mold-resistant paint – If repainting, use mold-resistant primers and VOC-free paints.
✔ Non-toxic bedding – Wash sheets weekly in hot water & use organic, non-toxic materials to reduce mold exposure in your sleep environment.✔ Check for hidden mold– Under sinks, behind drywall, in HVAC systems.
✔ EC3 Mold Spray & Laundry Additive – Neutralizes mold spores on surfaces, fabrics, and in the air. -
✔ High-quality and adequate proteins – Pasture-raised, grass-fed, wild-caught (rich in amino acids that support detox and repair).
✔ Healthy fats – Coconut oil, olive oil, ghee, avocado, wild salmon (essential for brain function and inflammation control).
✔ Tons of detox-supporting veggies – Cruciferous greens, beets, fresh herbs (help activate liver detox pathways).
✔ Prebiotic foods – Onions, garlic, leeks, asparagus, dandelion greens (feed beneficial gut bacteria to counteract mold-induced dysbiosis).
✔ Bone broth – Supports gut lining repair and provides minerals depleted by mold exposure.
✔ Fermented foods (if tolerated) – Sauerkraut, kimchi, coconut yogurt (can help rebalance the microbiome, but be mindful if histamine-sensitive).
✔ Glutathione-rich foods – Asparagus, spinach, avocados, sulfur-rich veggies (boosts the body’s ability to detox mold toxins).
✔ Mold-free coffee (if consuming) – Conventional coffee can be mold-contaminated; opt for lab-tested, mycotoxin-free brands.
✔ Cilantro & chlorella – Natural binders that help eliminate heavy metals and mold toxins.
✔ Turmeric & ginger – Potent anti-inflammatory and liver-supporting spices.
✔ Lemon water first thing in the morning – Helps flush the liver and support digestion.
✔ Bitter foods (artichokes, dandelion greens, radicchio) – Stimulate bile flow, which is key for detoxing mold toxins.
✔ Hydration with electrolytes – Mold exposure can deplete minerals; adding sea salt, coconut water, fulvic and humic acid, or trace minerals helps replenish. -
Daily Movement & Nervous System Regulation
✔ Walking daily + weight training – Supports detox and mitochondria function, boosts circulation, and enhances lymph flow.
✔ Breathwork + meditation – Even just 5 minutes to lower stress response and shift the body out of fight-or-flight mode.
✔ Lymphatic drainage support – Dry brushing, sauna, rebounding, manual massage (stimulates lymph flow to clear out toxins).
✔ Nasal irrigation – Neti Pot or saline rinse with distilled water (clears out mold spores inhaled from the air).
✔ Grounding (Earthing) – Walking barefoot on grass, sand, or soil helps regulate the nervous system and inflammation.
✔ Vagus nerve stimulation – Humming, singing, gargling, cold exposure, or craniosacral therapy to calm the nervous system and improve detox pathways.
✔ Cold plunges or contrast showers – Supports circulation, reduces inflammation, and enhances mitochondrial health.
✔ Sunlight exposure – Supports circadian rhythm, vitamin D production, and immune regulation.
✔ Epsom salt baths – Helps with detox and replenishes magnesium, which is often depleted by mold toxicity.
✔ Chiropractic care or craniosacral therapy – Helps regulate the nervous system and clear structural blocks affecting detox pathways.
✔ Breath-focused movement (yoga, Pilates, tai chi) – Lowers inflammation and supports detoxification.
✔ Infrared sauna – Encourages sweating out mold toxins and supports mitochondrial repair.
✔ Hydration before and after movement – Ensures proper detox support by keeping lymph and kidneys flushing efficiently.
Nutraceuticals for Mold Toxicity
If You've Been Exposed to Mold, You Know the Struggle
Mold doesn’t just mess with your sinuses. It can trigger chronic inflammation, gut dysfunction, immune dysregulation, and even neuroinflammation (hello, brain fog and anxiety).
And here’s the worst part: Mold mycotoxins don’t leave the body easily.
Your detox pathways (liver, kidneys, gut, lymphatic system) have to be working really well to process and eliminate them. And for a lot of people, those pathways are already sluggish from stress, poor diet, or just the sheer burden of modern toxins.
That’s where nutraceuticals come in.
Nutraceuticals are powerful, food-based compounds that do more than just nourish —they actively support your body’s ability to heal, repair, and fight back against inflammation, toxins, and illness. Think of them as nature’s way of giving your cells exactly what they need to detox, rebalance, and thrive.
From acemannan and betalains to colostrum and fulvic acid, these are the heavy hitters when it comes to mold recovery, immune resilience, and whole-body restoration.
The nutraceuticals listed here are ones my family and I have trusted for years. When I found out we had mold — and realized we were already taking the best supplements for mold toxicity — I felt a deep sense of gratitude. It was one of those moments where I could see God’s grace so clearly, guiding and providing before I even knew what we needed.
They have been shown to modulate the immune system and inflammation, support detox pathways, help repair the damage mold causes, and so much more.
Let’s take a look.
-
✔ Supports Immune Response & Detoxification
• Stimulates macrophages, the immune cells responsible for detecting and breaking down mold toxins.
• Increases phagocytosis, the process by which immune cells engulf and destroy toxins and pathogens.
• May bind to endotoxins, helping carry mold toxins out of the body.✔ Strengthens the Gut (Which Mold Loves to Destroy)
• Mold toxins contribute to leaky gut, where the intestinal lining becomes compromised.
• Acemannan supports intestinal epithelial cell regeneration, helping repair a damaged gut lining.
• Stimulates short-chain fatty acid (SCFA) production, which helps regulate gut inflammation and microbiome balance.
• Promotes the growth of beneficial gut bacteria while inhibiting harmful microbes.✔ Modulates IL-6 & Reduces Chronic Inflammation
• Mycotoxins trigger IL-6, a pro-inflammatory cytokine linked to chronic inflammation and immune dysregulation.
• Acemannan reduces IL-6 production, lowering systemic inflammation.
• Increases IL-10, an anti-inflammatory cytokine that helps regulate immune response.✔ Protects Brain Function & Cognitive Health
• Mold toxins cross the blood-brain barrier, leading to brain fog, anxiety, and mood imbalances.
• Acemannan supports microglial cell function, helping the brain’s immune system clear out toxins without overreacting.
• May help stimulate neurogenesis, supporting brain repair after toxic exposure.
How to Use Acemannan for Mold Detox✔ Take 6-8 capsules daily with or without food.
✔ Virtually tasteless. Capsules can be opened and be mixed into any food or drink for children, adults and even pets.The most potent & patented form of acemannan can be purchased HERE. Save 10% with code “Niccole10”
-
✔ Drastically Lowers IL-6 & TNF-α (Key Inflammatory Cytokines)
• Mold exposure causes chronic inflammation, leading to joint pain, brain fog, and immune dysfunction.
• Betalains significantly reduce IL-6 and TNF-α, helping control inflammation at its root.
• In one study, betalains lowered IL-6, TNF-α, and GRO-α (another inflammation marker) in osteoarthritis patients after just 10 days of supplementation.✔ Enhances Liver Detoxification
• Your liver is your main detox organ, and it takes a massive hit when exposed to mold.
• Betalains support phase II liver detoxification, helping break down and eliminate mold toxins.
• Boosts glutathione production, the body’s master detoxifier.
• Enhances bile production, which helps carry toxins out of the body through digestion.✔ Protects Mitochondrial Function (Energy Production)
• Mold exposure disrupts mitochondrial function, leading to chronic fatigue, weakness, and low energy.
• Betalains have been shown to protect and regenerate mitochondria, restoring cellular energy.
• Improve ATP synthesis, meaning your cells can produce more energy, more efficiently.✔ Reduces Neuroinflammation & Supports Cognitive Function
• IL-6 and TNF-α are highly active in neurodegenerative diseases like Alzheimer’s and are often elevated in mold-exposed individuals.
• Betalains inhibit IL-6 and TNF-α in the brain, reducing inflammation and restoring mental clarity.
• May help increase dopamine and serotonin levels, counteracting mold-related mood disturbances.
How to Use Betalains for Mold Detox✔ Take (1) capsule (Two) times daily apart from food.
The most potent & patented form of betalains can be purchased HERE. Save 10% with code “Niccole10” -
Core contains one serving (many people need more when dealing with mold) of Acemannan and Betalains, plus:
Modified Citrus Pectin✔ Binds & Eliminates Mold Toxins
• MCP binds to mold mycotoxins in the bloodstream and digestive tract, preventing them from recirculating.
• Unlike activated charcoal, MCP doesn’t deplete essential minerals or beneficial nutrients.
• Helps remove heavy metals and environmental toxins, which can further burden detox pathways.✔ Protects Against Mold-Triggered Inflammation
• Mycotoxins trigger chronic inflammation, leading to autoimmunity, fatigue, and brain fog.
• MCP reduces IL-6 and TNF-α, the inflammatory cytokines heavily linked to mold exposure.✔ Supports Gut Repair
• Mold disrupts gut integrity, contributing to leaky gut and food sensitivities.
• MCP helps restore the gut lining and rebalance the microbiome after mold exposure.Lactoferrin
✔ Fights Mold & Fungal Overgrowth
• Mold exposure increases fungal overgrowth in the gut, sinuses, and lungs.
• Lactoferrin has been shown to inhibit mold growth and reduce Candida & Aspergillus overgrowth.✔ Modulates Immune Function
• Mycotoxins suppress and dysregulate the immune system.
• Lactoferrin activates white blood cells, helping the immune system fight back—without overreacting.✔ Supports Gut Health
• Mold destroys beneficial bacteria, leading to gut dysbiosis and IBS-like symptoms.
• Lactoferrin promotes the growth of good bacteria while reducing harmful pathogens.Collagen
✔ Repairs the Gut Lining
• Mold toxins damage intestinal tight junctions, leading to leaky gut.
• Collagen rebuilds and seals the gut lining, preventing further toxin absorption.✔ Strengthens Joints, Skin & Hair
• Chronic inflammation from mold breaks down collagen, leading to joint pain, hair loss, and premature aging.
• Supplementing with collagen supports connective tissue repair and reduces joint discomfort.✔ Supports Detox Pathways
• Collagen contains glycine, proline, and glutamine, which fuel detoxification and help rebuild damaged tissues.
Colostrum✔ Repairs & Strengthens the Gut Lining
• Mold toxins damage the intestinal lining, contributing to leaky gut and systemic inflammation.
• Colostrum contains growth factors that promote gut cell regeneration and repair.
• Helps restore gut barrier integrity, reducing food sensitivities and toxin absorption.✔ Boosts Immune Function
• Mold exposure suppresses and dysregulates the immune system, making it harder to fight infections.
• Colostrum provides immunoglobulins (IgG, IgA, IgM) that help neutralize mold toxins.
• Supports a balanced immune response—strengthening defenses without triggering excess inflammation.✔ Reduces Chronic Inflammation
• Mycotoxins spike IL-6 and TNF-α, leading to fatigue, brain fog, and joint pain.
• Colostrum has been shown to reduce these inflammatory markers, helping the body recover.
Pine Bark Extract✔ Improves Oxygen Delivery & Circulation
• Mold exposure reduces blood flow to the brain, contributing to dizziness, fatigue, and cognitive issues.
• Pine bark extract increases nitric oxide production, enhancing circulation and oxygenation.
• Supports vascular health, helping to restore normal blood flow and energy levels.✔ Reduces Neuroinflammation & Protects the Brain
• Mycotoxins cross the blood-brain barrier, triggering inflammation and impairing brain function.
• Pine bark extract lowers IL-6 and TNF-α, two key inflammatory cytokines linked to mold-induced neuroinflammation.
• Helps prevent brain fog, mood swings, and cognitive decline caused by mold toxicity.✔ Supports Cognitive Function & Recovery
• Chronic inflammation disrupts neurotransmitter balance, contributing to anxiety and depression.
• Pine bark extract has been shown to support memory, focus, and overall brain resilience.
• Works synergistically with other antioxidants to protect neurons and restore cognitive clarity.
How to Use CORE for Mold Detox✔ Mix one packet with water or juice and drink daily.
✔ Take in the morning to kickstart liver detox pathways and cellular repair.
✔ For greater support, take twice daily, especially if experiencing mold-related fatigue, brain fog, or inflammation.
One packet a day is safe for toddlers and older. Core is virtually tasteless and can be mixed into an food or drink.
Core is patented by Alovea and can be purchased HERE. Save 10% with code “Niccole10”
Note: If I could only afford one Alovea product on the list, I would choose (2) packets of Core/day. -
If you're dealing with mold exposure, one of the biggest mistakes you can make is stirring up toxins without actually getting them out. That’s where fulvic and humic acids come in.
These naturally occurring compounds come from decomposed plant matter and act as negatively charged binders (modified citrus pecting is also negativel charged), meaning they grab onto positively charged toxins — like mold mycotoxins, heavy metals, and environmental pollutants — and escort them out of the body.
Most binders (like activated charcoal or bentonite clay) work only in the gut, but fulvic and humic acids go deeper—they penetrate cells, support mitochondrial function, and replenish minerals lost during detox.
Here are the Benefits of Fulvic and Humic Acids:
✔ Bind & Remove Mold Toxins
• Act as natural chelators, binding mycotoxins, heavy metals, and pesticides so they can be safely excreted.
• Unlike other binders, fulvic & humic acids don’t strip beneficial minerals.✔ Restore Cellular Energy (ATP Production)
• Mold toxins damage mitochondria, leading to fatigue and weakness.
• Fulvic acid recharges mitochondria, helping cells restore energy production.✔ Replenish Lost Minerals & Electrolytes
• Mycotoxins deplete critical minerals like magnesium, zinc, and selenium.
• Fulvic & humic acids help restore these essential nutrients, supporting detox and recovery.
Purchase Fulvic & Humic Acide HERE. The savings on Subscribe & Save is significant. -
✔ Restores Energy Production
• Mold toxins deplete thiamine, slowing ATP production and causing chronic fatigue.
• Thiamine helps mitochondria convert nutrients into usable energy, reducing mold-induced exhaustion.✔ Supports the Nervous System
• Neurological symptoms like brain fog, anxiety, and dizziness are common with mold toxicity.
• Thiamine nourishes the brain and nerves, helping restore cognitive function and regulate the stress response.✔ Flushes Out Mycotoxins
• Mold exposure overloads detox pathways, making elimination sluggish.
• Thiamine supports liver function and bile flow, helping clear out toxins more efficiently.
Purchase Thiamax HERE. -
✔ Instantly Absorbed for Maximum Effectiveness
• Traditional glutathione must pass through digestion, but HydraStat Nano-Technology delivers immediate absorption through the mucous membranes.
• Bypasses the gut, ensuring higher bioavailability and faster cellular support.✔ Neutralizes & Eliminates Mold Toxins
• Mold exposure depletes glutathione, making detox difficult and leaving toxins trapped in the body.
• Supports phase II liver detox, breaking down mycotoxins so they can be excreted through bile, urine, and stool.✔ Reduces Inflammation & Oxidative Stress
• Mold toxicity drives IL-6 and TNF-α, leading to brain fog, fatigue, joint pain, and immune dysfunction.
• Neutralizes oxidative stress, reducing inflammatory cytokines and protecting mitochondria from damage.✔ Supports Brain Function & Cognitive Clarity
• Mold toxins cross the blood-brain barrier, triggering neuroinflammation, anxiety, memory loss, and poor focus.
• Protects neurons, modulates microglial function, and helps restore cognitive function after toxic exposure.✔ Boosts Energy & Cellular Repair
• Mitochondria take a massive hit from mold, leaving people exhausted and unable to recover.
• Enhances ATP production, replenishing cellular energy and supporting deep tissue repair.✔ Improves Immune Function & Detox Pathways
• Mold exposure suppresses immune function, making people prone to infections and autoimmune reactions.
• Helps regulate immune response, enhancing detox efficiency and reducing histamine overload.✔ Enhances Sleep & Recovery
• Glutathione helps regulate circadian rhythms and restore deep, reparative sleep, which mold toxicity often disrupts.
• Works synergistically with magnesium and glycine for optimal sleep support.How to Use NutriSwish for Mold Detox
Swish 1–2 teaspoons in your mouth for 30–60 seconds, then swallow.
Take 2–3 times daily for fast-acting detox, immune support, and inflammation reduction.
Order NutriSwish HERE. Ordering on Subscribe & Save has a significant savings.
Think You Might Have Mold? Here’s a D.I.Y. Mold Inspection Checklist:
Check under all sinks for moisture, discoloration, or visible mold.
Turn the lights off and shine a flashlight upward on sink cabinet doors — this can reveal hidden water damage and ring patterns.
Take off light switch plates in bathrooms and check for ring patterns on the back—these can indicate past water exposure.
Baseboards near tubs, showers, and kitchen appliances (especially dishwashers).
Look for swollen baseboards, cracked/peeling/bubbling paint — all signs of hidden moisture damage.
Check behind toilets & under toilet tank lids for mold growth.
Inspect the attic with lights off, using a flashlight — mold often hides in insulation or on the underside of the roof.
Use a moisture meter (Drywall Reader) around:
All windows
All walls that back up to showers
Ceilings that are under showers
Additional Tip: If you find mold, DO NOT disturb it — scrubbing or spraying it can release spores into the air. Take pictures, document the damage, and move on to testing.
Test Your Home for Mold
If you suspect mold but can’t see it, testing is a good next step. Here are a few options:
At-Home Testing Kits:
EC3 Mold Screening Test – A simple, petri-dish-style test that lets you sample the air in your home. You’ll know within a few days if mold levels are high.
ERMI (Environmental Relative Moldiness Index) Test – A dust test you can order online. It analyzes DNA from mold species and gives you a detailed report on what’s in your home.
Home Air Quality Monitors – Some advanced air monitors (like Airthings) can detect mold risk based on humidity and VOC levels.
Professional Testing (If You Want to Be Sure):
Mold Inspection with Air Sampling – A professional can collect air samples to measure mold spore levels.
Infrared Camera Inspections – This detects hidden moisture (where mold thrives) behind walls and ceilings.
Tape Lift or Swab Tests – If you have visible mold, a professional can swab or lift a sample to determine the exact type of mold.
Additional Tip: If you’re renting, get proof of mold contamination before reporting it to your landlord. Some landlords will try to cover it up rather than fix it properly.
Test Yourself for Mold Exposure
If your home tests positive for mold, the next step is checking your body for signs of exposure.
Tests You Can Ask Your Doctor For:
Mycotoxin Urine Test – Detects mold toxins your body is excreting.
Mast Cell Activation Panel – Tests for mast cell activation syndrome (MCAS), a common mold-related issue.
CIRS Panel (Chronic Inflammatory Response Syndrome) – A group of blood tests that assess inflammation markers linked to mold toxicity.
Organic Acids Test (OAT) – Can reveal mold-related imbalances in gut bacteria and detox pathways.
Heavy Metals + Mold Cross-Reactivity Test – Mold toxins often go hand in hand with heavy metal accumulation.
Many conventional doctors won’t test for mold, so you may need to see a functional medicine or environmental medicine specialist.
Start Reducing Mold in Your Home
If testing confirms mold, take action ASAP — because you can’t heal if you’re still being exposed.
How to Start Cleaning Mold Safely
Follow the EC3 Mold Guide
Use EC3 Mold Solution Spray – One of the best non-toxic options for killing airborne mold spores. Spray it on everything — fabrics, furniture, air vents, walls.
EC3 Candles – Help reduce mold spores in the air. Light them in rooms where you spend the most time.
HEPA Air Purifiers – A high-quality HEPA air purifier (like IQAir or AirDoctor) removes mold spores from the air.
Dehumidifiers – Mold thrives in humidity, so keeping indoor humidity below 50% makes it harder for mold to grow.
DIY Cleaning Solutions – Vinegar, hydrogen peroxide, and grapefruit seed extract are safer alternatives to bleach (which doesn’t kill mold at the root).
Decide If You Need to Remediate or Move
If you catch mold early, cleaning and dehumidifying may be enough. But if there’s hidden mold behind walls, under flooring, or inside your HVAC system, remediation may be necessary.
DO NOT try to DIY Major Mold Removal. Disturbing mold releases spores into the air, which can make symptoms worse. Get a professional remediator who follows IICRC standards (not just a handyman with bleach).
In some cases, leaving the home may be necessary — especially if you’re dealing with major structural contamination. But that’s a last resort.
Trust Your Body
Mold toxicity is one of the most overlooked health issues — and because the symptoms look like so many other things (stress, allergies, aging, burnout), it’s easy to gaslight yourself into thinking it’s not that big of a deal.
But if you feel like something is off, trust that.
Start small.
✔ Test your home.
✔ Test yourself.
✔ Make small, manageable changes to reduce your exposure.
Moving Forward with Hope
We learned of our mold exposure just three weeks ago. I wish I would have known about mycotoxins sooner, but I’m choosing to share our journey as we go.
Our family has made the decision to move out of our leased home.
We know this next chapter comes with its own challenges — deep-cleaning our belongings, making tough decisions about what to keep, and settling into a new space. But despite the work ahead, we feel hopeful.
Hopeful that our bodies will continue to heal. Hopeful that the steps we’ve taken have given us a strong foundation. And hopeful that this move will be a turning point for our family’s health.
If you’ve been dealing with mold exposure, just know — you’re not alone. We’re in this with you. Our bodies are designed to heal.